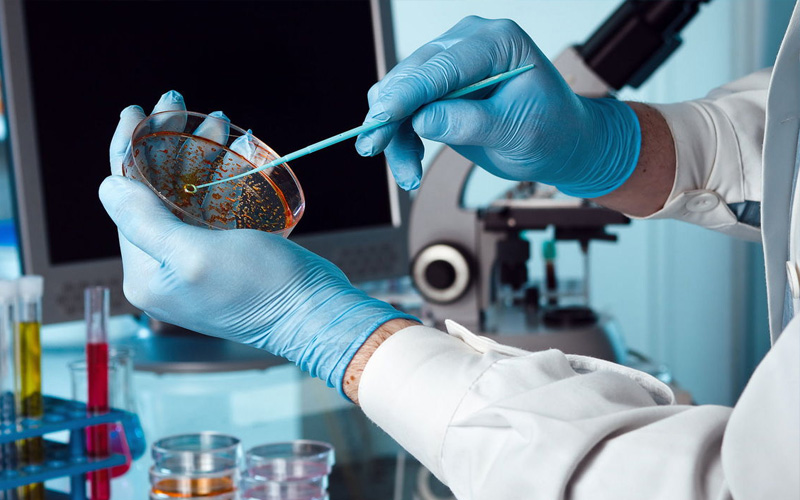

Todos necessitamos de cuidados com a nossa saúde. Sendo assim, exigir uma boa qualidade da água que utilizamos em nosso dia-a-dia é fundamental. Para que todos possamos desfrutar deste beneficio, a SoluInsect dispõe de técnicas e pessoas capacitadas para realização dos serviços de limpeza e desinfecção de reservatórios d'água.
Inicialmente, esgota-se toda água do reservatório (recomenda-se que o cliente feche os registros de água em tempo suficiente para o consumo da mesma, diminuindo desperdícios), em seguida retira-se todos os restos de materiais como papel, madeira, pedaços de ferro, lodo, entre outros, porventura existentes no interior do reservatório.
O reservatório é lavado com água de boa qualidade, tendo suas paredes limpas de maneira correta, em seguida é feita a desinfecção obedecendo as normas técnicas da CETESB D 3.860. Posteriormente executa-se uma segunda lavagem e a solução desinfetante é aplicado no reservatório, onde será eliminada através das torneiras, desinfectando também os canos. Finaliza-se o trabalho liberando a entrada da água no reservatório.
Ao término do trabalho a SoluInsect disponibilizamos um certificado de garantia e quando necessário as análises microbiológicas.